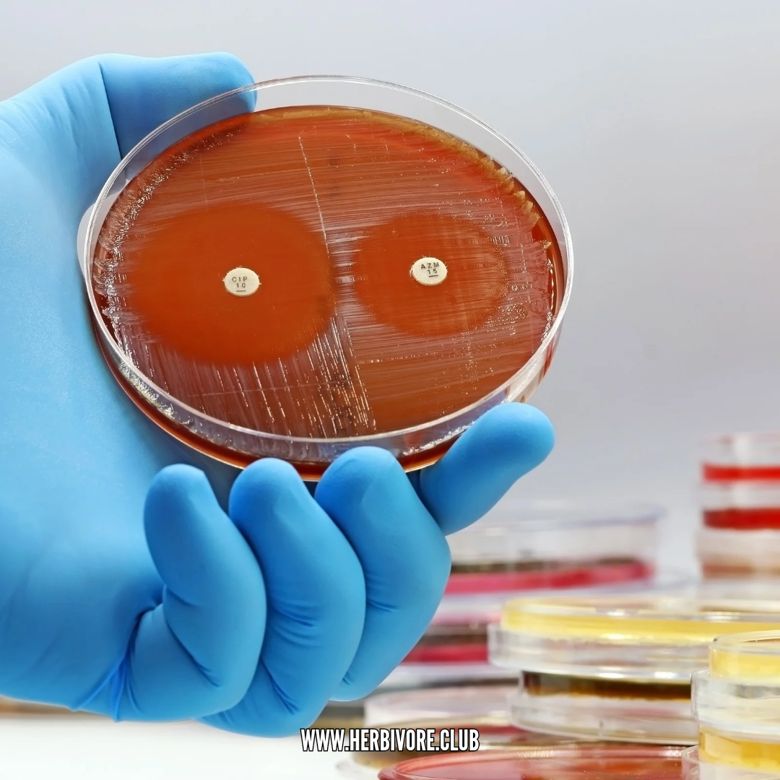

👉 Join the Movement! ➡️ Take the Vegan Pledge: https://drove.com/.2A4o 🌱
#philosophy #philosopher #philosophyquotes #quotes #veganshare

👉 Join the Movement! ➡️ Take the Vegan Pledge: https://drove.com/.2A4o 🌱
#philosophy #philosopher #philosophyquotes #quotes #veganshare



Many things throughout history, like human slavery, have been legal but morally wrong. One day, animal exploitation will also come to an end.
Which side of history will you be on? 🤔
Be on the right side of history. Be #vegan.

Many things throughout history, like human slavery, have been legal but morally wrong. One day, animal exploitation will also come to an end.
Which side of history will you be on? 🤔
Be on the right side of history. Be #vegan.
my brain:
don’t say it
don’t say it
don’t say it
don’t say it
don’t say it
Me: "Maybe you could go plant-based too for the dozens of species lost every single day?" 🦧
#OrangutanDay
#WorldOrangutanDay

my brain:
don’t say it
don’t say it
don’t say it
don’t say it
don’t say it
Me: "Maybe you could go plant-based too for the dozens of species lost every single day?" 🦧
#OrangutanDay
#WorldOrangutanDay
👉 See the impact of animal agriculture: https://3movies.wtf/cowsp 🐮
#water #sustainability #conservation #environmentalist #veganmeme

👉 See the impact of animal agriculture: https://3movies.wtf/cowsp 🐮
#water #sustainability #conservation #environmentalist #veganmeme
 is shown at the bottom.](https://cdn.bsky.app/img/feed_thumbnail/plain/did:plc:l664phxvt6vexdxlycpmtwhk/bafkreidp7zt2abpmjjpt42bi4u2re7scefh42ifnsmzc2icfyp3sppzuyq@jpeg)

👉 Start your vegan journey with FREE recipes: https://bit.ly/VeganFTA22 🌱
#meatfree #veganism #govegan #bekindtoanimals #empathy

👉 Start your vegan journey with FREE recipes: https://bit.ly/VeganFTA22 🌱
#meatfree #veganism #govegan #bekindtoanimals #empathy

Going to post one of these every day as a reminder.
More at bit.ly/world-revisited
#nature #biodiversity #veganism #animalethics

Going to post one of these every day as a reminder.
More at bit.ly/world-revisited
#nature #biodiversity #veganism #animalethics
#climatecrisis
www.theguardian.com/environment/...

#climatecrisis
www.theguardian.com/environment/...


That’s not a joke. That’s the same mindset as "They were asking for it.”
That’s not a joke. That’s the same mindset as "They were asking for it.”
open.substack.com/pu...

open.substack.com/pu...
Among them: a family with two kids who lived under occupation for years — the younger child was denied medical care.
Among them: a family with two kids who lived under occupation for years — the younger child was denied medical care.
An absolutely horrifying must-read series, 'The Viktoriia project', exposing how Russia is systematically detaining and torturing an estimated 16,000 Ukrainian civilians
www.theguardian.com/world/series...
An absolutely horrifying must-read series, 'The Viktoriia project', exposing how Russia is systematically detaining and torturing an estimated 16,000 Ukrainian civilians
www.theguardian.com/world/series...

